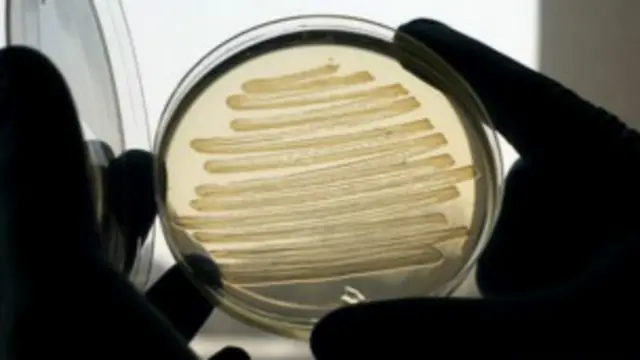
البكتريا

نوع من البكتريا ينتج وقودا حيويا شبيها بالديزل
يقول علماء في بريطانيا إنهم تمكنوا من التوصل إلى مجموعة من البكتريا التي يمكنها أن تنتج الوقود.
وأجرى الباحثون تعديلات وراثية على بكتريا تسمى "إي كولي"، لتحويل السكر إلى وقود، يتطابق إلى حد كبير مع الديزل التقليدي.
وقال الباحثون الذين نشرت دراستهم في دورية الأكاديمية الوطنية للعلوم إنه إذا اتسع في هذا الأمر، فربما يصبح هذا الوقود الصناعي بديلا مجديا للوقود الأحفوري.
وقال جون لوف، أستاذ البيولوجيا الاصطناعية في جامعة إكستر "بدلا من التوصل إلى بديل للوقود مثل بعض أنواع الوقود الحيوي، توصلنا إلى صنع وقود أحفوري بديل".
وأضاف "تعتمد الفكرة على أن شركات تصنيع السيارات، والمستهلكين، وبائعي الوقود بالتجزئة لن يلاحظوا الفرق، وقد يصبح ذلك جزءا آخر من سلسلة إنتاج الوقود".
مصانع الوقود
وهناك مساعٍ لزيادة استخدام الوقود الحيوي حول العالم، ففي الاتحاد الأوربي، استهدف استخدام أنواع الوقود القائمة على المحاصيل الزراعية في قطاع النقل والمواصلات بنسبة عشرة في المئة بحلول عام 2020.
لكن أغلب أشكال الديزل الحيوي والإيثانول الحيوي التي تستخدم حاليا، لا تتوافق تماما مع المحركات الحديثة.
فهناك نسبة من المواد (تصل إلى ما بين 5 و10 في المئة) يجب خلطها بالبنزين قبل أن تستخدم في أغلب المحركات الموجودة حاليا.
ومع ذلك، يختلف شكل الوقود المنتج من خلال بكتريا "إي كولي" المعدلة. وقال جون لوف "ما توصلنا إليه هو وقود يماثل تماما طول السلسلة المطلوبة للمحركات الحديثة، وكذلك نفس التركيبة المطلوبة".

وقال لوف إن هذا النوع من الوقود يمكن أن نسميه "وقود أحفوري حيوي".
واستخدم الباحثون - الذين مولت دراستهم شركة شل للنفط، ومجلس بحوث العلوم الحيوية والتكنولوجيا الحيوية - في التوصل إلى هذا النوع من الوقود سلالة من بكتريا "إي كولي" التي عادة ما تستهلك السكر وتحوله إلى دهون.
وباستخدام البيولوجيا الصناعية، حول الباحثون آليات عمل خلايا البكتريا حتي يُحول السكر إلى جزيئات وقود صناعي، بدلا من ذلك.
ومن خلال تغيير جينات البكتريا، تمكن الباحثون من تحويل هذه البكتريا إلى مصانع لإنتاج الوقود، لكن مع ذلك، لم تقم بكتريا "إي كولي" بإنتاج الكثير من وقود الألكان.
وقال لوف إن استخدام 100 لتر من البكتريا يؤدي إلى إنتاج مقدار ملعقة صغيرة من الوقود.
وأضاف "التحدي الذي أمامنا هو أن نزيد من الإنتاجية قبل أن نتمكن من الاتجاه نحو أي شكل من أشكال الإنتاج الصناعي، وقد حصلنا على نطاق زمني من ثلاث إلى خمس سنوات تقريبا من أجل القيام بذلك، ولمعرفة إن كان الأمر يستحق أن نمضي قدما في هذا الاتجاه".
كما يتطلع فريق البحث إلى معرفة إن كانت البكتريا تستطيع أن تحول أي منتجات أخرى إلى وقود، مثل النفايات البشرية أوالحيوانية.
الرصاصة السحرية
ويعد الوقود الحيوي بديلا للوقود الأحفوري، وأكثر توافقا مع البيئة، بينما يؤدي استخدام البنزين والديزل إلى انبعاث غاز ثاني أكسيد الكربون الذي يخزن في أعماق الأرض.
ومع ذلك، فإن الطاقة المستهلكة في زراعة ومعالجة المحاصيل المطلوبة من أجل عمل الوقود الحيوي هي أمر يجب أن يؤخذ في الاعتبار، إذ ذكر تقرير صدر مؤخرا عن مؤسسة تشاتام هاوس أن الوقود الحيوي مكلف، وأسوأ للمناخ من الوقود الأحفوري.
ووفقا لجيرانت إيفانز، مستشار الوقود الحيوي بمؤسسة NNFCC، المعروفة سابقا باسم المركز الوطني للمحاصيل غير الغذائية، فستحتاج هذه الأمور إلى النظر فيما يتعلق بالوقود الذي ينتج من خلال البكتيريا.
وأضاف إيفانز "هذا يُوسع من المصادر المحتملة التي يمكن أن تستخدم لعمل الديزل، لكننا لا نزال في حاجة إلى التفكير في أن هذا يأتي من الأرض، وأن عامل الاستدامة يجب أن يؤخذ بعين الاعتبار".
وأشار إلى أن "هذه ليست الرصاصة السحرية، لكنها وسيلة أخرى من بين الوسائل المتاحة".




























